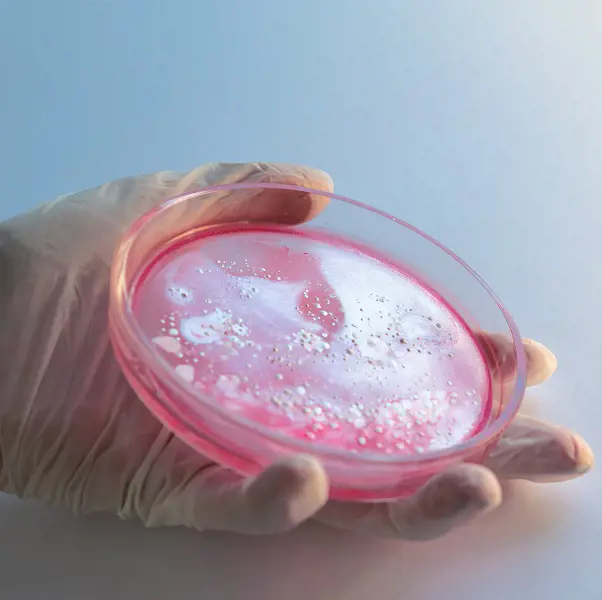

היחידה לפריון הגבר ובנק הזרע ב"ליס" שבאיכילוב הוקמה בשנת 1975, ומאז טופלו בה אלפי מטופלים ומטופלות, והיא שותפה ללידתם של תינוקות רבים.
היחידה עוסקת בשני תחומים עיקריים: פריון הגבר והפעלת בנק זרע, ומטפלת בקהלים שונים בהתאם:
גברים או זוגות הפונים או מופנים מהקהילה לצורך הערכה וטיפול בפריון הגברי, ונשים המבקשות להרות באמצעות תרומת זרע.
זימון תור ליחידת פריון הגבר ובנק הזרע
צוות היחידה
-
 מידע נוסף
מידע נוסף
ד"ר נגה פוקס ויצמן
מומחית למילדות, גינקולוגיה ופריון, רופאה בכירה ביחידת הIVF ומנהלת פריון הגבר ובנק הזרע -
 מידע נוסף
מידע נוסף
ד"ר שימי ברדה
מנהל מעבדת בנק הזרע ופריון הגבר -
 מידע נוסף
מידע נוסף
ד"ר שניר דקלו
רופא בכיר, מומחה באורולוגיה, מומחה פריון הגבר, מנהל תחום אנדרולוגיה, המחלקה האורולוגית -
 מידע נוסף
מידע נוסף
פרופ' פואד עאזם
מנהל המכון לפריון והיחידה להפריה חוץ גופית, מנהל השירות לשימור פוריות והשירות לתרומת ביציות, ביה"ח "ליס" ליולדות ונשים
תחומי פעילות
זוגות לא מעטים חווים אי הצלחה בנסיונות להרות, ורבים מהם פונים לבירור ויעוץ בנושא. ע"פ הספרות המדעית, ב-40-50% מהזוגות ימצא גורם זכרי כלומר: הצד הגברי במשוואה יימצא "תורם" לבעיית הפוריות. ברור פוריות ביחידה לפריון הגבר יבוצע לשני בני הזוג תוך שימת דגש על בריאות הגבר ופוריותו.
בקישור זה תמצאו את המידע המקיף והמלא על תהליך הבירור של פריון הגבר והבדיקות הנדרשות לבירור פוריות
השגת הריון מתרומת זרע בעידן המודרני הפכה לפתרון מקובל ונגיש להקמת משפחות חדשות ומאושרות בישראל ובכלל. בנק הזרע בליס - איכילוב פועל מזה שנים והוקם על מנת לסייע לנשים וזוגות להביא ילד לעולם באמצעות תרומת זרע.
קהל היעד שיכול להיעזר בתרומת זרע מגוון: נשים יחידניות מבחירה, נשים בזוגיות חד מינית ונשים שבן זוגן אינו פורה.
על מנת להתחיל בתהליך יש לתאם תור לפגישה בבנק הזרע יש להגיע לפגישה עם המסמכים הבאים:
- צילום ת.ז וספח
- כל הבדיקות הנדרשות למטופלת - בקישור זה מפורטות מכלול הבדיקות אותם יש לבצע לצורך פתיחת תיק נתרמת בבנק הזרע.
- טופס התחייבות מקופ"ח (טופס 17) ל"ביקור רופא מומחה" (קוד 99242).
תהליך יבוא זרע מחו"ל באמצעות בנק הזרע אשר במכון לפריון באיכילוב הינו תהליך פשוט ונוח.
לשאלות נפוצות ופרטים נוספים על השירות
ניתן לקבל לווי פסיכולוגי במסגרת מכון הפריון. הלווי כולל פגישות ייעוץ בודדות או תהליך ממוקד וממושך יותר. הפגישות הינן פרטניות, זוגיות וקיימת גם קבוצת תמיכה ליחידניות לעתיד.השירות ניתן ע"י גב' ג'ודית קדוש קובלסקי, פסיכולוגית קלינית ופסיכולוגיךת המכון באמצעות טפסי 17 מקופות החולים. ליצירת קשר יש לפנות ל 03-6925753, או למייל judithko@tlvmc.gov.il. למידע נוסף >
מידע בנושא פריון גברי ובנק הזרע
ליס - כתבות ומאמרים-

מידע כללי בנק הזרע
אילו בדיקות נדרשות, קודים לטפסי התחייבות ועד -

טיפולי פריון
טיפולי פריון - שאלות ותשובות- טיפולים במסגרת היחידה לפוריות ובנק הזרע -

תרומת זרע מתורם ישראלי
בחירת תורם הזרע היא החלטה משמעותית ואנו נלווה אתכן לאורך כל התהליך ונסייע לבחור בתורם המתאים ביותר לצרכים ולמאפיינים האישיים שלכם -
ייבוא מנות זרע מחו"ל
על ייבוא מנות זרע מחו"ל במסגרת בנק הזרע ב"ליס" -

בדיקות פוריות לגבר
מרבית הגברים יגלו בעיית פוריות כאשר יפנו לבירור רפואי, זאת לאחר שניסו מספר חודשים להרות ללא הצלחה. -

מידע לגברים המעוניים לתרום זרע
בנק הזרע - על תרומת זרע באיכילוב -

שירות פסיכולוגי של מכון הפריון
אספקטים פסיכולוגים של טיפולי פוריות - מסגרות טיפול -

המדריך המלא להורה הגאה
איך מתחילים בעצם? למי זה מתאים? האם כדאי לפנות לייעוץ רפואי ולאיזה רופא צריך לגשת? מהם טיפולי פוריות המתאימים?
בדיקות, טיפולים וניתוחים
- רחיצת זרע והכנתו להזרעה תוך רחמית
- טיפול ניתוחי באי פריון על רקע גברי
- הלוספרם - בדיקה לזיהוי שברים בדנ"א של תאי הזרע
